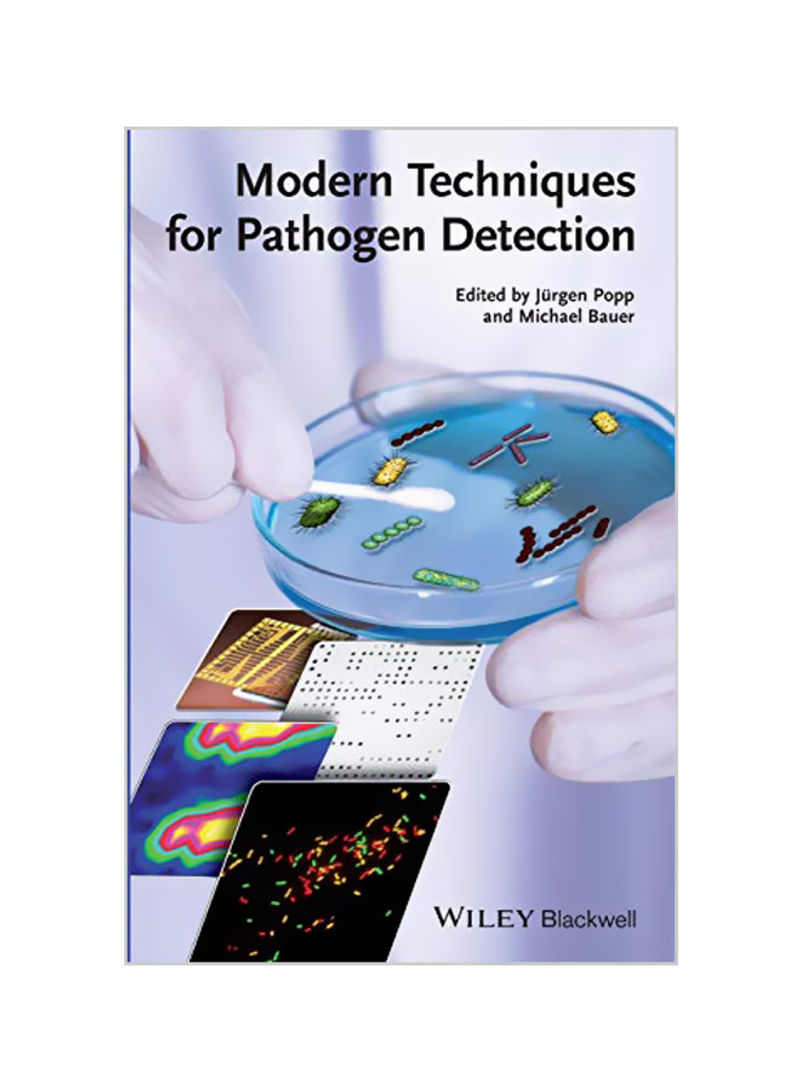
Modern Techniques for Pathogen Detection Hardcover

Modern Techniques for Pathogen Detection Hardcover
Recommend
Sort by
Rating
Date
Specifications
Author 1
J?rgen Popp
Book Description
This outstanding overview sets a new standard for a methods book on pathogen detection. The first chapter provides an outline of currently used routine methods, including their background, strengths and weaknesses, as well as comparing them to newer methods. The following chapters then cover novel methods already in wide use and which are still more experimental for routine purposes. An invaluable resource for all medical laboratories and clinical institutions dealing with infectious diseases.
ISBN-10
3527335161
ISBN-13
9783527335169
Language
English
Publisher
Wiley-VCH Verlag GmbH
Publication Date
42163
Number of Pages
352
About the Author
Jurgen Popp is Professor at the Friedrich-Schiller-University Jena where he is Director of the Institute of Physical Chemistry. He is also Director of the Institute of Physical High Technology (IPHT) Jena. In the German National Research Network on biophotonics he serves as the speaker. Professor Bauer is the chair of the Integrated Research and Treatment Center for Sepsis at the Friedrich Schiller University Jena. Prof. Bauer graduated from the medical school of the Saarland in 1990 before moving to the Johns Hopkins Hospital for 2 years. Since 2003 he is full professor at the University of Jena.
Editor 1
Jürgen Popp
Editor 2
Michael Bauer